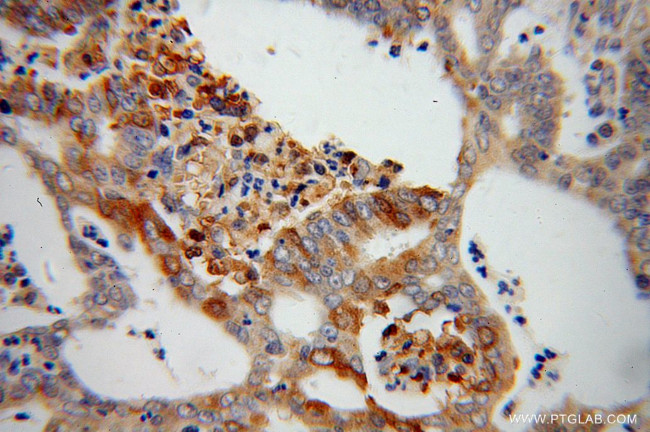
PARN Antibody in Immunohistochemistry (Paraffin) (IHC (P))

Search
Proteintech
PARN Polyclonal Antibody
{{$productOrderCtrl.translations['antibody.pdp.commerceCard.promotion.promotions']}}
{{$productOrderCtrl.translations['antibody.pdp.commerceCard.promotion.viewpromo']}}
{{$productOrderCtrl.translations['antibody.pdp.commerceCard.promotion.promocode']}}: {{promo.promoCode}} {{promo.promoTitle}} {{promo.promoDescription}}. {{$productOrderCtrl.translations['antibody.pdp.commerceCard.promotion.learnmore']}}
产品信息
13799-1-AP
种属反应
已发表种属
宿主/亚型
分类
类型
抗原
偶联物
形式
浓度
规格
纯化类型
保存液
内含物
保存条件
运输条件
产品详细信息
Immunogen sequence: MEIIRSNFK SNLHKVYQAI EEADFFAIDG EFSGISDGPS VSALTNGFDT PEERYQKLKK HSMDFLLFQF GLCTFKYDYT DSKYITKSFN FYVFPKPFNR SSPDVKFVCQ SSSIDFLASQ GFDFNKVFRN GIPYLNQEEE RQLREQYDEK RSQANGAGAL SYVSPNTSKC PVTIPEDQKK FIDQVVEKIE DLLQSEENKN LDLEPCTGFQ RKLIYQTLSW KYPKGIHVET LETEKKERYI VISKVDEEER KRREQQKHAK EQEELNDAVG FSRVIHAIAN SGKLVIGHNM LLDVMHTVHQ FYCPLPADLS EFKEMTTCVF PRLLDTKLMA STQPFKDIIN NTSLAELE (1-347 aa encoded by BC050029)
靶标信息
The protein encoded by this gene is a 3'-exoribonuclease, with similarity to the RNase D family of 3'-exonucleases. It prefers poly(A) as the substrate, hence, efficiently degrades poly(A) tails of mRNAs. Exonucleolytic degradation of the poly(A) tail is often the first step in the decay of eukaryotic mRNAs. This protein is also involved in silencing of certain maternal mRNAs during oocyte maturation and early embryonic development, as well as in nonsense-mediated decay (NMD) of mRNAs that contain premature stop codons. Alternatively spliced transcript variants encoding different isoforms have been found for this gene.
仅用于科研。不用于诊断过程。未经明确授权不得转售。
生物信息学
蛋白别名: Deadenylating nuclease; Deadenylation nuclease; poly(A)-specific ribonuclease (deadenylation nuclease); Poly(A)-specific ribonuclease PARN; Polyadenylate-specific ribonuclease; unnamed protein product
基因别名: 1200003I18Rik; DAN; DKCB6; PARN; PFBMFT4; RGD1565449
UniProt ID: (Human) O95453, (Mouse) Q8VDG3
Entrez Gene ID: (Human) 5073, (Mouse) 74108, (Rat) 360464